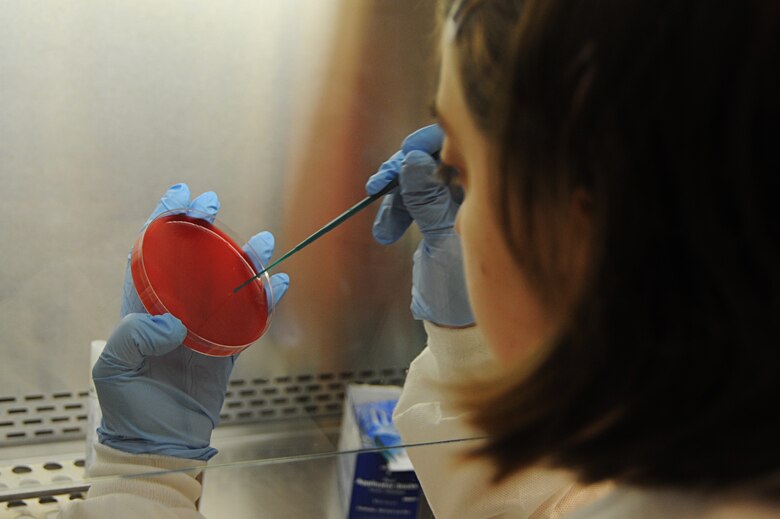
scott afb lab

product description:

Scott Air Force Base
scott afb lab Discover cheap clothes, shoes and accessories for men at Our shop Outlet. Shop the latest menswear collection at cheap prices.

Scott Air Force Base
scott afb lab Discover cheap clothes, shoes and accessories for men at Our shop Outlet. Shop the latest menswear collection at cheap prices.
Product reviews:




Owen
2026-06-13 iphone Xs
space defense » Albuquerque Journal scott afb lab
scott afb lab

Newman
2026-06-14 iphone 7 Plus
Scott Air Force Base scott afb lab
scott afb lab

Solomon
2026-06-11 iphone 7
Meanwhile at Scott AFB. : AirForce scott afb lab
scott afb lab

Humphrey
2026-06-19 iphone X
Air Force 'innovation cell' at Scott scott afb lab
scott afb lab

Customer Reviews:
| Full Name: | |
| Title: | |
| Description: | |
| Rating Value: | |
| Time: | 2026-06-20 18:33:08 |
Customers who viewed this item also viewed: